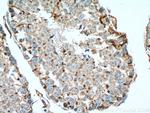
SDF4 Antibody in Immunohistochemistry (Paraffin) (IHC (P))

Search
Proteintech
SDF4 Polyclonal Antibody
{{$productOrderCtrl.translations['antibody.pdp.commerceCard.promotion.promotions']}}
{{$productOrderCtrl.translations['antibody.pdp.commerceCard.promotion.viewpromo']}}
{{$productOrderCtrl.translations['antibody.pdp.commerceCard.promotion.promocode']}}: {{promo.promoCode}} {{promo.promoTitle}} {{promo.promoDescription}}. {{$productOrderCtrl.translations['antibody.pdp.commerceCard.promotion.learnmore']}}
产品信息
10517-1-AP
种属反应
宿主/亚型
分类
类型
抗原
偶联物
形式
浓度
规格
纯化类型
保存液
内含物
保存条件
运输条件
产品详细信息
Immunogen sequence: GHVSWDEYK VKFLASKGHS EKEVADAIRL NEELKVDEET QEVLENLKDR WYQADSPPAD LLLTEEEFLS FLHPEHSRGM LRFMVKEIVR DLDQDGDKQL SVPEFISLPV GTVENQQGQD IDDNWVKDRK KEFEELIDSN HDGIVTAEEL ESYMDPMNEY NALNEAKQMI AVADENQNHH LEPEEVLKYS EFFTGSKLVD YARSVHEEF (155-362 aa encoded by BC006211)
靶标信息
This gene encodes a stromal cell derived factor that is a member of the CREC protein family. The encoded protein contains six EF-hand motifs and calcium-binding motifs. This protein localizes to the Golgi lumen and may be involved in regulating calcium dependent cellular activities.
仅用于科研。不用于诊断过程。未经明确授权不得转售。
生物信息学
蛋白别名: 45 kDa calcium-binding protein; Cab45; SDF-4; Stromal cell-derived factor 4; unnamed protein product
基因别名: CAB45; PSEC0034; SDF-4; SDF4
UniProt ID: (Human) Q9BRK5, (Mouse) Q61112, (Rat) Q91ZS3
Entrez Gene ID: (Human) 51150, (Mouse) 20318, (Rat) 155173